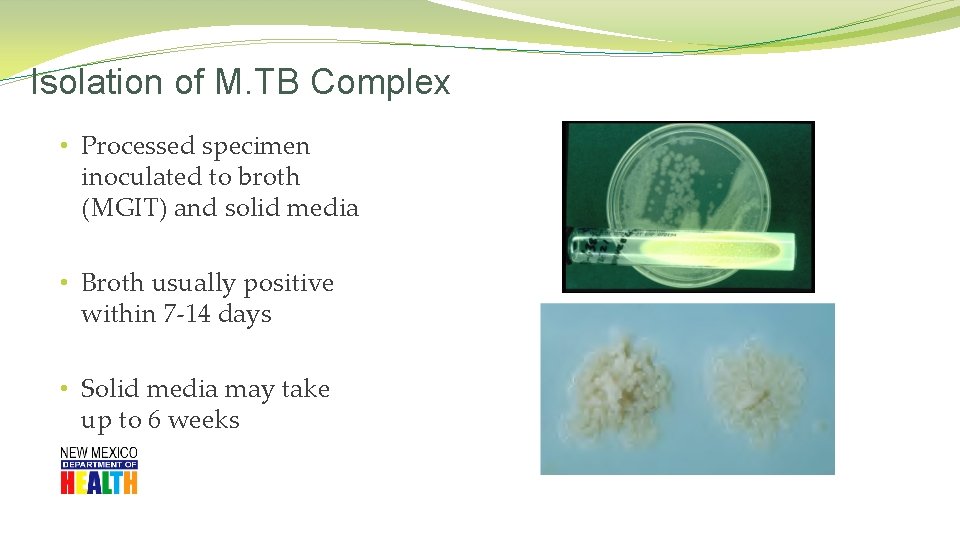
Isolation of M. TB Complex • Processed specimen inoculated to broth (MGIT) and solid
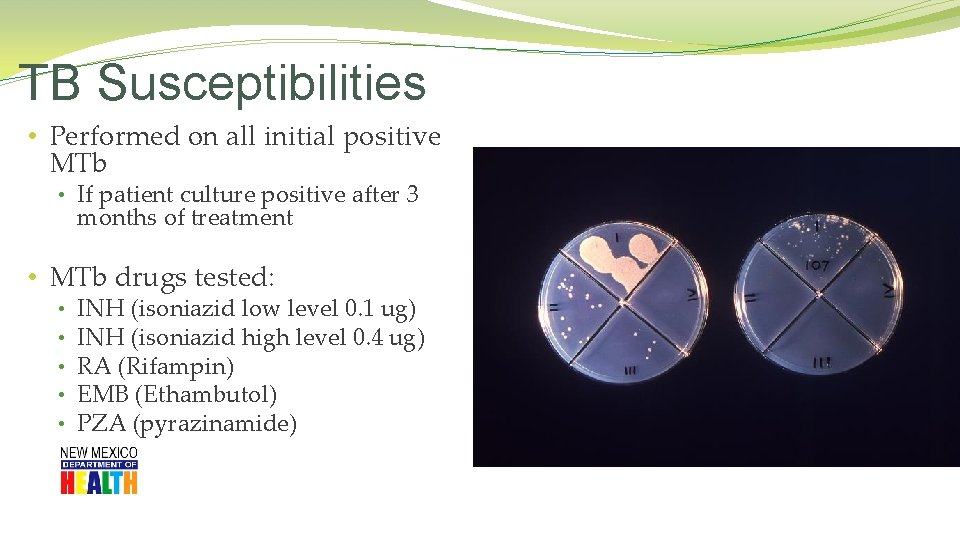
TB Susceptibilities • Performed on all initial positive MTb • If patient culture positive

Fundamentals of TB New Mexico Department of Health

Fundamentals of TB New Mexico Department of Health Tuberculosis Program

Overview �Transmission, pathogenesis and epidemiology of tuberculosis �Screening for tuberculosis infection �Review TST Health History and TST Consent Form �Administering, reading and interpreting TST �Patient referral information

TB: An Ancient Disease Tuberculosis has plagued humanity for centuries. Has been known by a variety of names: • • • Phthisis (Hippocrates 450 BC) • Consumption • Wasting disease • White plague Evidence of TB has been found in ancient mummies over 4, 000 years old. • • Albert R. Zink, Christophe Sola, Udo Reischl, Waltraud Grabner, Nalin Rastogi, Hans Wolf and Andreas G. Nerlich. Characterization of Mycobacterium tuberculosis Complex DNAs from Egyptian Mummies by Spoligotyping. Journal of Clinical Microbiology. 2003 Jan; 41(1); 359 -367 La Miseria by Cristóbal Rojas (1886).

TB History in New Mexico �Between 1880 – 1940 � people sought the cure for TB in NM due to the arid climate �Up to 60 Sanatoriums �By 1920: � 10% of the New Mexico population were residents seeking health remedies ST. ANTHONY'S SANATORIUM and HOSPITAL A fully equipped Sanatorium for the treatment of pulmonary, gland, bone, joint and laryngeal tuberculosis. Rates $50. 00 to $60. 00 per month. Medical care extra. Operated by the "Sisters of Charity of Leavenworth, Kansas. " EAST LAS VEGAS, NEW MEXICO [March 1935 advertisement in the CHEST Journal]

TB: A Silent Public Health Epidemic � In 2014, � 6 million new TB cases reported to WHO � TB killed 1. 4 million people � (1. 1 million HIV neg. , 0. 4 HIV positive) � 2 -3 billion people infected with TB � 30, 000 people die EACH Week � 4100 people per day � Leading infectious disease killer of adults worldwide � Economic Impact � Toll on global economy � - $12 billion/year � By 2050 cost to global economy � - $16. 7 trillion � Personal Impact � Loss 4 months of work � 30% of annual income � Isolation World Health Organization Global Tuberculosis Report 2015 http: //www. who. int/tb/publications/global_report/en/

TB Anywhere is TB Everywhere 3 out of every 5 New Mexico TB cases occur among foreign born persons

TB Anywhere is TB Everywhere The 22 countries shown on map have 80% of the TB cases in the world!

TB in the US

TB Case Rates, * United States, 2014 D. C. < 3. 0 (2014 national average) >3. 0 Slide provided by CDC *Cases per 100, 000.

TB in New Mexico

TB in New Mexico �County Data

What is tuberculosis? • Tuberculosis is a disease caused by a bacterium • Mycobacterium tuberculosis. • The bacteria usually infects the lungs…. . • but it can infect any part of the body such as the bone, pleura, liver, kidney, spine, and brain and other organs.

M. tuberculosis • Discovered by Robert Koch in 1882 • Slightly curved, rod shaped bacilli • 0. 2 - 0. 5 microns in diameter and 2 - 4 microns in length • Aerobic • Non-motile • Thick lipid cell wall • Acid fast • Multiplies slowly (once every 18 - 24 hours) • Can remain dormant for decades Source: CDC/Dr. George P. Kubica, 1979

Active TB Disease � Symptomatic: • Persistent cough > than 3 weeks • Weight loss • Fever/chills • Night sweats • Fatigue • Bloody sputum • May spread TB to others • May have positive skin test/IGRA • Sputum culture positive • Occasionally cases of culture negative TB do occur

Transmission

Transmission • Person to Person via through the air when a person with TB disease: • • Coughs Laughs Talks Sings

Transmission • Tuberculosis cannot be spread by: • Sharing dishes and utensils • Using towels and linens • Handling food • Brief contact

Transmission �In 1882, Robert Koch discovered the organism responsible for Tuberculosis. � 68 years later…. �In the 1950’s, Dr. Richard L. Riley work with guinea pigs as a Johns Hopkins Hospital researcher proved that particles the size of a mote of dust could transmit tuberculosis. 1 CDC/ Merle J. Selin 1. Aerial dissemination of pulmonary tuberculosis. A two-year study of contagion in a tuberculosis ward. 1959. <http: //www. ncbi. nlm. nih. gov. offcampus. lib. washington. edu/pubmed/7785671> Riley RL, Mills CC, Nyka W, Weinstock N, Storey PB, Sultan LU, Riley MC, Wells WF.

Transmission

Transmission: Risk of Infection Probability TB will be transmitted: • Infectiousness of person with TB • Concentration of droplet nuclei in the air • Duration of exposure • Susceptibility of the contact • Majority of contact do not become infected • If infected, 10% lifetime risk of developing active TB •

Latent TB Infection (LTBI) Person: • Asymptomatic • Not contagious • Normal chest x-ray • Positive skin test or Quantiferon Gold Bacteria: • Alive but inactive • Not replicating • Surrounded (walled off) by body’s defense system

Active TB Disease Person: • Symptomatic • Infectious • May have positive skin test/IGRA Granuloma breaks down and tubercle escape and multiply Bacteria: • Active and multiplying • Cause damage • Can disseminate throughout the body • Grow on culture • Damage causes abnormal x-ray or imaging

Making the diagnosis �Symptom Screening �Cough �Weight loss �History of potential exposure to TB �TB skin test or IGRA results �CXR – red flags of CXR chart �Collect sputa x 3; �may collect every 8 hours �at least one specimen early AM CDC/ Minnesota Department of Health, R. N. Barr Library; Librarians Melissa Rethlefsen and Marie Jones �Medical exam �Extra-pulmonary sites

Know the RED FLAGS of TB Disease Chest X-ray Reports • Pneumonic Process - frequently in the right upper lobe. • Interstitial Infiltrates. • Possibility of cavitary lesion. • Mass, lesion, often needing a CT Scan to further define. • Pleural effusion (considered TB until proven otherwise). • Parenchymal disease. • Nodular densities consistent with old granulomatous disease. • RUL densities. • Nodular densities. • Linear parenchymal changes. • Hilar or Perhilar adenopathy. • Thickening/blunting of right costophrenic angle. CDC/Charles Farmer Probably Not TB Disease Negative no infiltrates no active disease no tuberculosis Normal clear List created by: Mary V. Muench, RN, TB Program Coordinator and Carol Clark, RN, TB Program Nurse, Florida Department of Corrections 2003. This is not intended to be all-inclusive and as with any test must be considered with the clinical picture of the patient.

AFB SMEAR Fluorescent Stain � Grading: � 4+ (Numerous) � 3+ (Moderate) � 2+ (Few) � 1+ (Rare) � (Negative smear) Ziehl-Neelsen Stain

NAAT/PCR (Nuclei Acid Amplification Test) �Perform on ALL patients who are TB Suspects �Sputum only �Sputum Smear positive & smear negative �Takes about 2 -4 hours
Isolation of M. TB Complex • Processed specimen inoculated to broth (MGIT) and solid media • Broth usually positive within 7 -14 days • Solid media may take up to 6 weeks
TB Susceptibilities • Performed on all initial positive MTb • If patient culture positive after 3 months of treatment • MTb drugs tested: • • • INH (isoniazid low level 0. 1 ug) INH (isoniazid high level 0. 4 ug) RA (Rifampin) EMB (Ethambutol) PZA (pyrazinamide)

TB Disease: Treatment Regimens �Four regimens recommended for treatment of culture-positive TB �Initial phase: standard four drug regimens (INH, RIF, PZA, EMB), for 2 months �Continuation phase: (RIF & INH) additional 4 months �(may be up to 7 months)

Can a HCW read their own TST? 1. Yes, if they work for the TB Program. 2. Yes, if they have received a state sponsored TST practicum. 3. No, Negativo, Nien!

HIGH risk for TB Infection • Contacts of infectious TB cases • Recently arrived immigrants from TB endemic countries • Health care workers • Persons who live/work in institutional settings • (shelters, nursing homes, correctional facilities) • Persons with compromised immune systems • (children < 4 years, other immunocompromised) • Patients in renal dialysis units • Person using TNF-Alpha Blockers • Medically undeserved/ low-income groups • Persons who live or stay in overcrowded, poorly-ventilated environments • Substance abusers, especially IVDU • Homeless • Persons with inadequate health care • Migrant workers

HIGH risk for progression to TB disease • Persons recently infected • Contacts and TST Convertors • Individuals with abnormal Chest X-ray • compatible with past TB • Children <5 years of age • Certain medical conditions: • Diabetes; TNF-alpha blockers; HIV+; in addition to: • Cancers , Prolonged corticosteroid or other immunosuppressed therapies, Chronic renal failure/hemodialysis, Organ transplant recipients, & Low body weight

Diagnosing TB Infection �Two types of TB Testing available �TB Skin Test �IGRA (Immune Gamma Release Assay) � QFT � � � & T. Spot Blood test Measure immune reactivity to Mycobacterium tuberculosis Does NOT interact with BCG!

Tuberculin Skin Testing (Mantoux) �Mantoux is only skin test currently used. Multiple puncture test (tine test) is inaccurate �The tuberculin used in the Mantoux skin test is also known as purified protein derivative or “PPD” CDC/ Gabrielle Benenson

Mantoux TST: Not a perfect test. �Sensitivity; �ability to correctly identify TB Infection �Specificity: � correctly identify those who do Not have TBI

Purified Protein Derivative (PPD) �Storage and handling �Store at 35 -46 F. in refrigerator or in cooler with ice packs � Do not freeze, � do not store on refrigerator door �Keep out of light �Date and initial when vial is opened. � 30 -day shelf life once vial is opened �Avoid pre-filling syringes

Administering the TST �Standard Precautions for administering �Use a tuberculin syringe � 27 gauge with 1/2 inch attached need �Dose: � 0. 1 ml of tuberculin (5 TU PPD) �Site: � Standard site – Left forearm � Alternate site – Right forearm �Route: � Intradermally using 5 -15 degree angle

Administering the TST

Incorrect placement

Reading the TST Reaction �Read reaction 48 -72 hours after injection �Measure the diameter of induration across the forearm �Induration = hard dense raised formation �Erythema = reddening of the skin (do not measure) • Record result in millimeters (mm) • (‘ 0’mm = no reaction)

Reading the TST Reaction �If client returns after 72 hours measure and record induration, then �If TST is read as negative, repeat TST �You can read a positive TST up to 7 days �Hypersensitivity reactions: � usually occur shortly after injection � subsides within 24 hours.

TST Interpretation Cut Points – ATS/CDC >5 mm is considered positive in • Close contacts of infectious TB cases • (known or suspected) • HIV-infected persons • (known or suspected) • - Fibrotic changes on CXR consistent with prior TB • Patients with organ transplants and/or those receiving immunosuppressed treatments • This group should be tested by Public Health

TST Interpretation Cut Points – ATS/CDC > 10 mm is considered positive in �Recent immigrants from high prevalence countries �IVDU, known to be HIV neg. �Residents and employees of high-risk congregate settings �Mycobacteriology lab personnel �Children < 4 years of age/ children and adolescents exposed to adults at high risk �Persons with medical conditions that place them at high risk of progression to TB disease

TST Interpretation Cut Points – ATS/CDC > 15 mm is considered positive • persons with no risk factors

False negative reactions Technical factors �Incorrect method of administration; �Incorrect interpretation; �Improper storage or contamination of PPD Host Factors • Recent TB infection • (< 3 months) • Anergic (HIV) • Very young age • < 3 months/age • Other viral, bacterial, fungal infections • Live virus vaccinations • Overwhelming TB disease

Live, Attenuated Vaccines • MMR, varicella, oral polio, oral typhoid, and yellow fever vaccines • may temporarily suppress response to tuberculin • What you should do: • Administer TST at same visit as vaccine • OR • Apply TST first and give vaccine when TST is read • OR • Delay TST until at least 4 -6 weeks after vaccine administered

Two-Step TST Method 1 st TST Negative Repeat TST in 1 -3 Weeks _______________________ 2 nd TST Negative Person likely does not have TB Infection Positive Boosted reaction due past infection

False positive reactions Causes; • Infection with NTM (non-tuberculosis mycobacteria) Vaccination with BCG (bacille Balmette-Guerin) • used in high prevalent countries • Size of reaction (3 mm-19 mm) doesn’t predict the degree of protection. (50% of vaccinated infants do not react to TST) • Reactions wane 5 -10 years after inoculation • Large positive +TST reaction usually indicate a M. Tb infection • BCG history should not preclude skin testing for LTBI • Do not alter the interpretation of a TST reaction due to a past BCG vaccination

The TST Health History and Consent Form

TST Health History/Consent Form Demographic Information �Patient identification �Good address & contact information �Physician/PCP identification �To notify of results of TST & referral for CXR if positive TST �Refer to public health if: � +TST and CXR complete �Public Health provide tx for TBI and Nurse Case Management

Purposes �Targeted data collection �Minimum information required…… � Should a TST be administered? � Is this a positive TST result for this patient? � Should the patient be referred for additional medical evaluation? �Client’s PCP �Informed consent for testing

Informed Consent �Informed consent for testing �Educational materials in patient’s preferred language �www. cdc. gov/tb �Importance of returning for TST reading �Written reminder helpful �Txt/email reminder – perhaps?

Allergies �True allergic reactions to PPD are rare �Do not confuse with … �Erythema �Vesiculation �Severe, necrotic reactions to TST

Current Medications �Prescription, OTC, herbal �Clues to other medical conditions �Risk factors for TBI and/or disease progression �False negative TST reactions �Potential drug-drug interactions, if treated

Referral Process • Physician/PCP or LPHO? • Refer to PCP for CXR following +TST unless • S/S of active TB disease refer to Department of Health • Prior coordination with LPHO is recommended • Fax form to physician/PCP or LPHO • F/U telephone call • See LPHO contact list in information packet • Fax form to NMDOH TB Program • (505) 827 -0163 • Provide copy of results to patient

Treatment of TBI - Adults • INH (900 mg) & Rifapentine (900 mg) once weekly x 12 weeks • • Must be given by DOT (directly observed therapy) Isoniazid 5 mg/kg (300 mg) daily for 9 months (270 doses) • Isoniazid 15 mg/kg (900 mg) twice weekly 9 months (76 doses) • Given by DOT (directly observed therapy) • Rifampin 10 mg/kg (600 mg) daily for 4 months (120 doses) • • INH-resistant , rifampin-susceptible source case INH intolerant • Rifampin/PZA 2 month regimen • no longer recommended – severe hepatotoxicity & death

TB Program Contacts Diana Fortune RN BSN TB Program Manager 505. 827. 2473 Deborah Isaacks RN BSN TB Nurse Consultant 505. 827. 2471 Benita Cook RN TB Nurse Consultant 575. 528. 5108
- Slides: 57